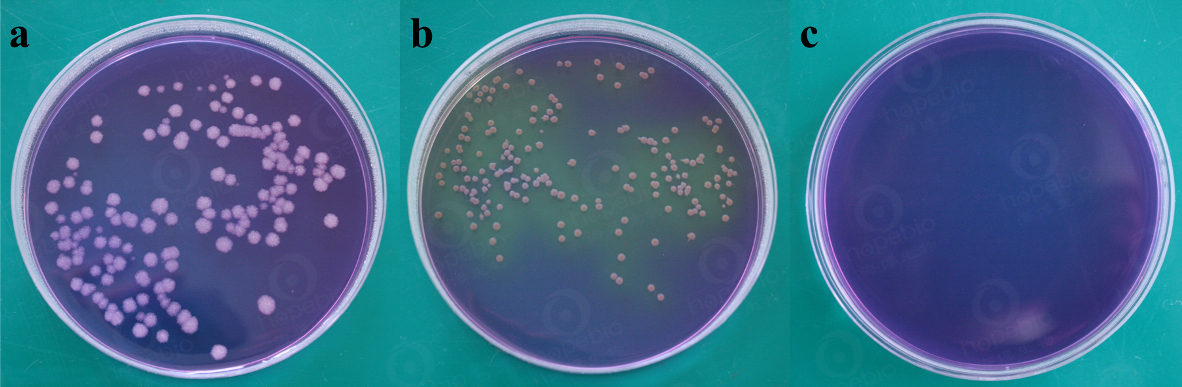
葡萄糖酪胨琼脂

万千商家帮你免费找货
0 人在求购买到急需产品
- 详细信息
- 文献和实验
- 技术资料
- 英文名:
Dextrose Casein-peptone Agar
- 保质期:
3年
- 供应商:
青岛海博生物
- 规格:
250g
成分(g/L)
| 酪蛋白胨 | 10.0 |
| 葡萄糖 | 5.0 |
| 溴jia酚紫 | 0.04 |
| 琼脂 | 12.0 |
| pH值6.8 ± 0.2 | 25℃ |
用法:称取本品 27g,加热搅拌溶解于 1000ml 蒸馏水中,分装,121℃高压灭菌 15 分钟,备用
葡萄糖酪胨琼脂上不同细菌是生长特征:
a:枯草芽孢杆菌,b: 蜡样芽孢杆菌,c: 空白对照
葡萄糖酪胨琼脂原理和使用方法:http://www.hopebiol.com/asphtml/refere9689.htm
风险提示:丁香通仅作为第三方平台,为商家信息发布提供平台空间。用户咨询产品时请注意保护个人信息及财产安全,合理判断,谨慎选购商品,商家和用户对交易行为负责。对于医疗器械类产品,请先查证核实企业经营资质和医疗器械产品注册证情况。
文献和实验从特异青霉(Penicillium notatum)等霉菌和蜂蜜中发现的酶。它能催化 D-葡萄糖 O2 D-葡糖酸(的δ -内酯) H2 O2 的反应。 EC1. 1. 3. 4.特异青霉( P. notatum)的酶以其显有抗菌性而引入注意。因此,也有葡糖氧化酶( notatin)的称呼,现已清楚,抗菌性是由于反应生成的 H2 O2 具灭菌作用。提纯物含有 2分子的 FAD,作为电子受体,除 O2 外,也能与 2, 6,二氯酚、靛酚反应。该酶对葡萄糖具有特异性。米氏
又称右旋糖。一种单糖,含醛基的已糖。固体状态为白色结晶,溶于水稍有甜味,有旋光性,其水溶液旋光向右。广泛存在于生物体内,为某些双糖(如蔗糖、麦芽糖等)和多糖(如淀粉、纤维素等)的组成成分。游离的葡萄糖存在于某些植物的果实(如葡萄)和动物血液中,是生物体中的主要能源物质。人体血液中的葡萄(血糖)含量相对恒定,正常人空腹和安静时血糖浓度为80~120毫克%。中枢神经系统几乎全部依赖血糖的供应作为能源,一旦血糖下降到80毫克%时可能出现糖尿现象。工业上葡萄糖由淀粉水解制得,60年代应用微生
癌症代谢百年之谜又有新解!癌细胞并不是故意浪费葡萄糖,而是因为「有心无力」
导读 葡萄糖是食物中常见的糖,是人体最重要的营养物质之一。长期以来,科学家们观察到癌细胞倾向于以惊人的速度消耗葡萄糖。乍一看,这似乎很有道理,毕竟随着肿瘤的迅速生长和癌细胞的扩增,每个细胞都必须复制其全部内容物。 但这种现象的背后存在一个问题,即癌细胞不能非常有效地利用葡萄糖,他们没有从葡萄糖中吸取所有的能量,而是将大部分能量作为废物释放出来。 早在 1921 年,德国科学家 Otto Warburg 就发现癌细胞以非常高的速率消耗葡萄糖,癌细胞不像正常分化的细胞那样使用氧气来消耗
技术资料暂无技术资料 索取技术资料










